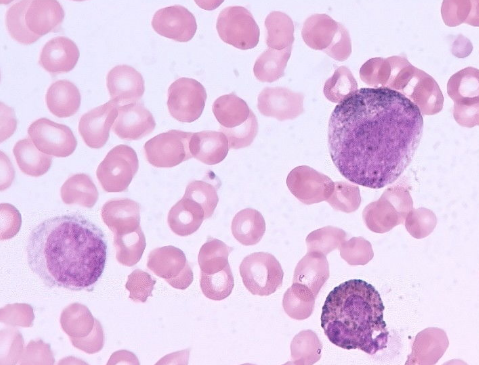

第二代酪氨酸激酶抑制剂达沙替尼比第一代抑制剂甲磺酸伊马替尼更有效地治疗费城染色体阳性的急性淋巴细胞白血病(ALL)。最近发表在权威杂志《美国医学会肿瘤学》上的一项三期随机临床试验表明,达沙替尼在治疗费城染色体阳性急性淋巴细胞白血病(Ph ALL)患儿方面比伊马替尼更有效此外,研究表明,达沙替尼对中枢神经系统白血病有良好的控制作用,而不使用预防性脑照射。
在中国的20家医院进行了一项公开的临床试验,中国儿童癌症组共纳入225例,其中189例随机分为大沙替尼80 mg/m2或伊马替尼300 mg/m2。研究小组在JAMA肿瘤学杂志上写道,“在一项中期分析显示,达沙替尼能产生更好的结果”,这是以三年无事件生存为基础的。经过26.4个月的中位随访和意向分析,达司替尼组四年无事件生存率(71.0%)明显高于伊马替尼组(48.9%)。复发率分别为19.8%和34.4%,孤立性中枢神经系统复发率分别为2.7%和8.4%。各组间毒副反应发生率无显着性差异(P>0.05)。达沙替尼与化疗联用主要出现的毒性包括血液学毒性,如3级或4级发热中性粒细胞减少、败血症和菌血症。10%以上的患者为非血液学、非感染性3级或4级不良事件,仅限于丙氨酸转氨酶升高和天冬氨酸转氨酶升高。其他3级或4级不良事件为胸腔积液、水肿、出血和心力衰竭。没有报告肺动脉高压或肺动脉高压的事件。
研究证实达沙替尼治疗费城染色体阳性急性淋巴性白血病儿童比伊马替尼更有效。 达沙替尼的价格虽有所下降,但依旧有一些儿童由于家庭经济状况而放弃治疗,更多的家庭愿意选择碧康制药所生产的达沙替尼,效果和成分和原研药无异,在印度第一药房购买只需1300元,给每个家庭带去了生的希望!